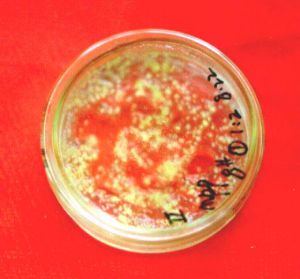
愈傷組織

簡要概述
 黑暗培養下菸草愈傷組織
黑暗培養下菸草愈傷組織詳述
 肉原生質體愈傷組織
肉原生質體愈傷組織愈傷組織的形成
 草莓花葯愈傷組織
草莓花葯愈傷組織起動期是指細胞準備進行分裂的時期。用於接種的外植體的細胞,通常都是成熟細胞,處在靜止狀態。起動期是通過一些刺激因素(如機械損傷、改變光照強度、增加氧等)和激素的誘導作用,使外植體細胞的合成代謝活動加強,迅速進行蛋白質和核酸的合成。機械損傷能誘導植物體細胞開始分裂,如傷口上會出現愈傷組織。在植物組織培養中沿用了愈傷組織這一名詞,但是植物組織培養中誘導外植體細胞分裂形成的愈傷組織,大都不是損傷的結果。外源的生長素類物質對誘導細胞開始分裂效果很好,因此生長素類物質在植物組織培養中得到廣泛套用,常用的有2,4-二氯苯氧乙酸、萘乙酸、吲哚乙酸和細胞分裂素等。
分裂期是指外植體細胞經過誘導以後脫分化,不斷分裂、增生子細胞的過程。處於分裂期的愈傷組織的特點是:細胞分裂快,結構疏鬆,顏色淺而透明。
外植體的脫分化因植物種類、器官來源及其生理狀況的不同而有很大差別。例如,菸草、胡蘿蔔等植物的脫分化比較容易,禾本科植物的脫分化比較難;花的脫分化比較容易,莖、葉的脫分化比較難;幼嫩組織的脫分化比較容易,成熟的老組織脫分化比較難。
愈傷組織的培養
 鳳梨的愈傷組織
鳳梨的愈傷組織愈傷組織的繼承培養:在外植體上形成以後,愈傷組織的繼承培養在已充分發育,但沒有出現老化現象之前,應及時從外植體上分離下來,轉入繼代培養基上進行繼代培養。分離是必要的措施,繼代培養時若連同外植體就會影響愈傷組織的產量和質量,可能是由於殘存的外植體在死亡過程中會產生某些有毒物質,愈傷組織會出現老化、粘化及不正常分化等現象。一般情況下,從外植體上分離的愈傷組織須經過4~6周的培養才能得到充分的發育。為了增殖發育良好的愈傷組織,繼代培養是有效的措施。在良好的培養條件下,甘蔗愈傷組織可繼代一年以上而不喪失分化能力。
影響甘蔗愈傷組織繼代培養的主要因素是激素。為協調繼代培養中既要維持愈傷組織增殖生長良好、又要保持愈傷組織的分化能力的矛盾,就必須篩選最佳的激素濃度。有報導指出,2,4-D(2~3mg/L)對保持愈傷組織不分化是有效的,但隨繼代培養次數的增加,其分化綠苗的能力也隨之下降。
 樹的發達的愈傷組織
樹的發達的愈傷組織甘蔗愈傷組織在除去生長素或降低生長素濃度的培養基上,即能發生器官的再分化。在甘蔗的組織培養中,有些品種的愈傷組織對生長素有較強的吸收和分解能力,甚至在含有一定濃度生長素的誘導或繼代培養基上亦能迅速分化成苗。影響甘蔗愈傷組織分化成苗的因素有愈傷組織的質量和大小、培養基、光照等。愈傷組織的大小對分化具有明顯的影響,接種時愈傷組織塊不宜小於5mm。
光照對甘蔗愈傷組織分化綠苗具有較好的促進作用,在無光照條件下分化出的是黃化苗,見光後又會返綠。一般在採光條件好的培養室,用自然散射光就可滿足要求。在採光差條件的培養室則需加人工輔助光,通常用日光燈為輔助光源,光照強度1500~2000Lx,光照時間12小時。至於培養基對分化的影響,則認為適宜的生長素與細胞分裂素配比有利於甘蔗愈傷組織的綠苗分化。甘蔗不同品種、不同材料愈傷組織的分化所要求的最佳激素配比不同,常用的分化培養基是“MS+NAA(0.5~1.5mg/L)+BA(0.5~1.0mg/L)”,也有同時使用IBA(0.5~2.0mg/L)的。
組織培養過程中的酚污染會影響培養效果。酚污染程度與外植體細胞的多酚氧化酶活性有關。甘蔗莖尖、嫩莖切段及靠近節處的幼嫩葉鞘均有較高的多酚氧化酶活性,所以這些組織的外植體接種後的酚污染也嚴重。培養基中添加的細胞分裂素物質有提高多酚氧化酶活性的作用,培養過程中的酚污染程度常隨細胞分裂素濃度的提高而加重。在培養基中使用0.1~0.5%的活性碳,有減輕酚污染的作用,也有助於根的形成。
功能用途
葉肉原生質體愈傷組織
葉肉原生質體愈傷組織實際成果
 銀杏形成的愈傷組織
銀杏形成的愈傷組織